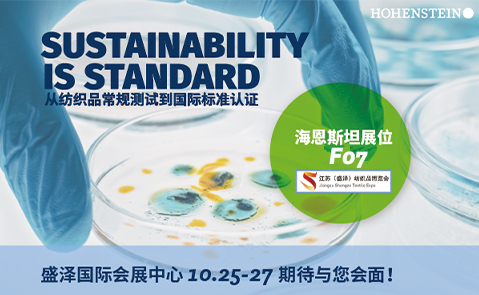

中国 - 中文
返回

时间:
2022年10月25-27日
地点:盛泽国际会展中心
展位:F07
盛泽纺博会依托盛泽庞大的纺织产业集群优势和市场优势,为国内外客商搭建推介展示、招商交易、学习交流的立体平台,共同推动纺织时尚产业发展,树立行业新标杆。海恩斯坦期待与您的会面与交流!


2022年10月25-27日
地点:盛泽国际会展中心
展位:F07
盛泽纺博会依托盛泽庞大的纺织产业集群优势和市场优势,为国内外客商搭建推介展示、招商交易、学习交流的立体平台,共同推动纺织时尚产业发展,树立行业新标杆。海恩斯坦期待与您的会面与交流!